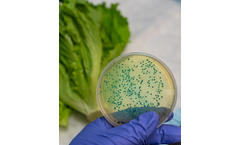
Smart - Food Safety and Recall Management Database Software

- Home
- Software
Refine by
Applications
- Water monitoring solutions for construction and mechanical industry
- Water monitoring solutions for offices and commercial buildings industry
- Water monitoring solutions for shopping centres sector
- Water monitoring solutions for care homes sector
- Water monitoring solutions for hospitality sector
- Water monitoring solutions for retail sector
- Software Solutions for Industrial Products & Manufacturing
- Software Solutions for Consumer Products
- Software Solutions for Retail
Smart Environmental Software
35 software items found
Premium
Manufactured by:Smart Storm Ltd. based inCaernarfon, UNITED KINGDOM
Remote monitoring is becoming an increasingly essential part of environmental monitoring and data collection. Smart Storm’s entire USI and USM range of smart instruments can be remotely monitored through our Windows based industrial IoT platform using a 4G modem that provides global ...
by:Smart Flow based inLondon, UNITED KINGDOM
Monitor all your properties water usage and costs in real-time. Receive instant alerts to any water related ...
by:SmartFoodSafe based inDorval, QUEBEC (CANADA)
Facilitate fast, safe, and compliance-ready user account management to secure access and manage all the internal and external ...
by:SMART Software based inEffingham, ILLINOIS (USA)
Find relief in knowing where your cash is at all times. Our all-in-one management tool is the premium solution to help you better manage your ATM Business! A premium ATM software solution. Built to help you manage the flow of cash between the bank and terminal. ...
by:Foobot—Airboxlab SA based inLuxembourg, LUXEMBOURG
Heating and cooling are the largest consumers in buildings but still, people inside often don’t feel comfortable. That’s because HVAC management is a highly complex problem — where AI has much to improve. ...
by:Velis based inKrakow, POLAND
Faster Entries And Exits With Our Premier Vehicle-Identification And Barrier-Control Application. Make your facility safer, reduce costs, and improve service quality with automation that combines easy-to-use software and cutting-edge technologies like LPR, RFID, CCTV, and ...
by:SmartFoodSafe based inDorval, QUEBEC (CANADA)
Replace traditional audit checklists with powerful digital applications to automate audit processes and improve compliance ...
Manufactured by:Berghof Membranes Technology (BMT) based inLeeuwarden, NETHERLANDS
As manufacturing industries grow to meet the demand of an ever-increasing population, the need for quality process water used in manufacturing processes and the high volume wastewater/effluent resulting from these processes have led companies to invest in more efficient wastewater treatment ...
by:SmartFoodSafe based inDorval, QUEBEC (CANADA)
Streamline laboratory process, increase workflow efficiency and improve employees and customer ...
by:EcoLogic Systems - part of ACC Environmental Consultants, Inc. based inOakland, CALIFORNIA (USA)
SMART Human Resource Management Software manages employee information, training, certifications and OSHA compliance records. It’s the perfect human resource software solution for small ...
by:Smart City Water Inc. based inVaughan, ONTARIO (CANADA)
VO-SWMM software offers a dual drainage modelling solution by connecting the EPA-SWMM engine with GIS and LIDAR data preparation ...
by:SmartFoodSafe based inDorval, QUEBEC (CANADA)
Transform environmental monitoring digitally to achieve fully automated mapping, scheduling, and pre-defined corrective actions in maintaining a safe and hygienic ...
by:EcoLogic Systems - part of ACC Environmental Consultants, Inc. based inOakland, CALIFORNIA (USA)
Tracking and managing routine equipment maintenance and calibration on an ongoing basis is a difficult task for organizations with a large number of vehicles or equipment. And failure to properly maintain equipment can prove costly due to reduced life, additional repair costs and equipment down time. Spreadsheet and paper-based solutions have severe limitations because they cannot be easily ...
by:SmartFlow based inNew York City, NEW YORK (USA)
SMART FLOW offers a comprehensive remote monitoring software designed to optimize water efficiency and mitigate water-related issues without upfront hardware costs. The software integrates AI and machine learning to identify anomalies such as leaks, human errors, or faulty appliances in real-time. It provides continuous monitoring and alerting to help businesses reduce water usage, control bills, ...
by:EcoLogic Systems - part of ACC Environmental Consultants, Inc. based inOakland, CALIFORNIA (USA)
SMART Training Management Software System manages training requirements for multiple job classifications, automates the registration process, and provides alerts when training or certifications are past ...
by:SmartFoodSafe based inDorval, QUEBEC (CANADA)
Stay on top of your supply chain risks by having access to commodity, country and Industry specific food safety recall ...
Manufactured by:FS Brainard & Co. based inBurlington, NEW JERSEY (USA)
The Smart Meter-Master Program enables the user to program all of the hardware configured Smart Meter-Master input and output channels. You can select 2-wire or 3-wire Sensus, Neptune, and Elster connections, and, if you want an encoder output to match an encoder input, you simply select ‘pass-thru’, in which case the encoder output will exactly match the encoder input. Configuration ...
Manufactured by:Inplox Water Systems Pvt Ltd. based inMumbai, INDIA
SMART is an automation platform which optimizes systems to improve treatment efficiency, consistency and reduce operational costs. The SMART platform enables remote system control, fine-tuning and real-time troubleshooting. All INDRA systems come inbuilt with SMART. SMART platform can also automate 3rd party conventional ...
by:SmartFoodSafe based inDorval, QUEBEC (CANADA)
Streamline product release processes with automated verification of specification and improve product compliance in real ...
Manufactured by:Datamatic, Inc. based inPlano, TEXAS (USA)
Did you know that 85% of Americans have smartphones? That’s why our smartphone-based manual reading app is the perfect solution for locating, reading, monitoring and billing all your gas, water and electric meters. Simply download the SPMR app to any Android-based smartphone to get started. And unlike complicated meter reading systems, SPMR requires no extensive training. By tapping into ...